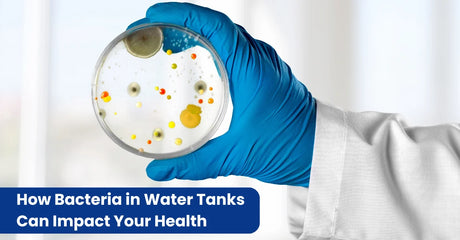

HOCL Pool Shock vs. Trichlor: Which Is Better for Your Pool in 2026?
Looking for the best pool shock treatment? You've probably heard about HOCL pool shock and trichlor. Both keep pools clean, but they work very differently. Choosing the wrong one can make...
E-Com Cabin |